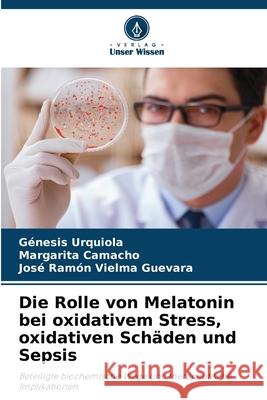
Die Rolle von Melatonin bei oxidativem Stress, oxidativen Schäden und Sepsis Urquiola, Génesis, Camacho, Margarita, Vielma Guevara, José Ramón 9786208687632
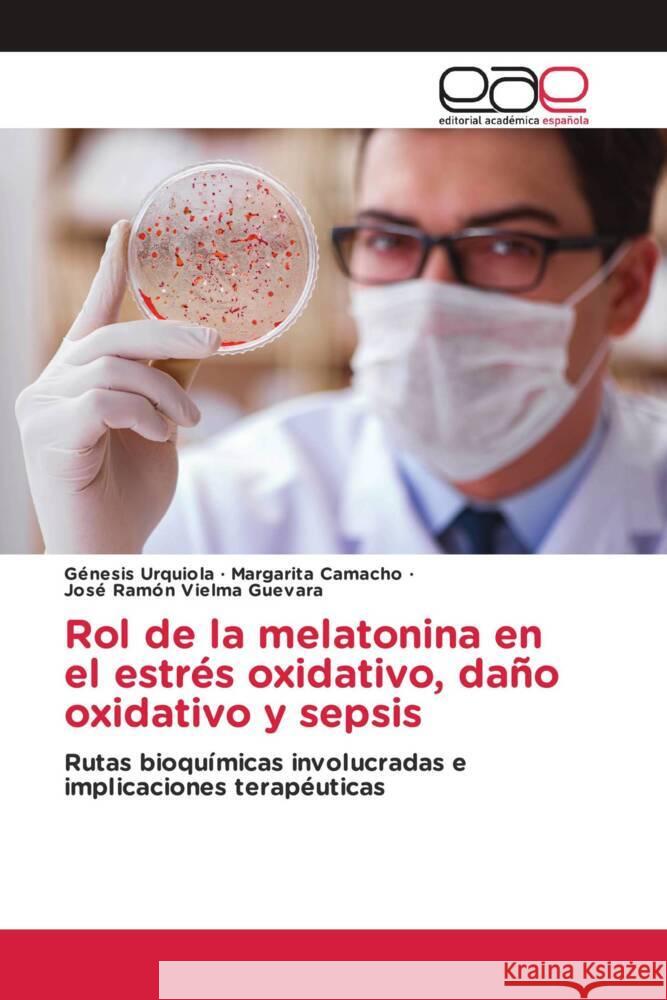
Rol de la melatonina en el estrés oxidativo, daño oxidativo y sepsis Urquiola, Génesis, Camacho, Margarita, Vielma Guevara, José Ramón 9786200032294

Wyniki wyszukiwania:
wyszukanych pozycji: 22
 |
Blastocystis spp. Infection: Update on Metabolism
ISBN: 9786200850416 / Angielski / Miękka / 2020 / 132 str. Termin realizacji zamówienia: ok. 10-14 dni roboczych. |
cena:
276,87 |
 |
Rola melatoniny w stresie oksydacyjnym, uszkodzeniach oksydacyjnych i sepsie
ISBN: 9786208687656 / Polski / Miękka / 2025 / 68 str. Termin realizacji zamówienia: ok. 10-14 dni roboczych. |
cena:
196,36 |
 |
Ruolo della melatonina nello stress ossidativo, nel danno ossidativo e nella sepsi
ISBN: 9786208687663 / Włoski / Miękka / 2025 / 68 str. Termin realizacji zamówienia: ok. 10-14 dni roboczych. |
cena:
196,36 |
|
Die Rolle von Melatonin bei oxidativem Stress, oxidativen Schäden und Sepsis
ISBN: 9786208687632 / Niemiecki / Miękka / 2025 / 72 str. Termin realizacji zamówienia: ok. 10-14 dni roboczych. Um die allgemeinen Konzepte der freien Radikale, des oxidativen Stresses und der oxidativen Schädigung sowie die in In-vivo- und In-vitro-Modellen gewonnenen Erkenntnisse über den potenziellen Einsatz von Melatonin bei verschiedenen bakteriellen Infektionen (Gram-positiv und Gram-negativ) und der Entwicklung von Sepsis zu beschreiben, haben wir eine qualitative systematische Überprüfung mit Informationsvalidierungskriterien durchgeführt und dabei sieben Suchmaschinen, Metasuchmaschinen und Datenbanken verwendet: Google Scholar, WebMD, Trip, Medscape, PubMed, NICE und Scielo, mit dem...
Um die allgemeinen Konzepte der freien Radikale, des oxidativen Stresses und der oxidativen Schädigung sowie die in In-vivo- und In-vitro-Modellen ge...
|
cena:
196,36 |
 |
Role of melatonin in oxidative stress, oxidative damage and sepsis
ISBN: 9786208687625 / Angielski / Miękka / 2025 / 64 str. Termin realizacji zamówienia: ok. 10-14 dni roboczych. To describe the general concepts of free radicals, oxidative stress, oxidative damage and the evidence obtained in in vivo and in vitro models on the potential use of melatonin in different bacterial infections (Gram positive and Gram negative) and the development of sepsis, we performed a qualitative systematic review with information validation criteria, with the use of seven search engines, meta-search engines and databases: Google Scholar, WebMD, Trip, Medscape, PubMed, NICE, and Scielo, which resulted in the retrieval of 380.792 documents using a combination of keywords in English and...
To describe the general concepts of free radicals, oxidative stress, oxidative damage and the evidence obtained in in vivo and in vitro models on the ...
|
cena:
196,36 |
|
Rol de la melatonina en el estrés oxidativo, daño oxidativo y sepsis
ISBN: 9786200032294 / Hiszpański / Miękka / 2025 / 68 str. Termin realizacji zamówienia: ok. 10-14 dni roboczych. |
cena:
196,36 |
 |
Papel da melatonina no stress oxidativo, danos oxidativos e sépsis
ISBN: 9786208687748 / Portugalski / Miękka / 2025 / 68 str. Termin realizacji zamówienia: ok. 10-14 dni roboczych. |
cena:
196,36 |
 |
Biocombustibles en Venezuela
ISBN: 9786139432660 / Hiszpański / Miękka / 2024 / 84 str. Termin realizacji zamówienia: ok. 10-14 dni roboczych. |
cena:
196,36 |
 |
La Agroecología en Venezuela
ISBN: 9783639640243 / Hiszpański / Miękka / 152 str. Termin realizacji zamówienia: ok. 10-14 dni roboczych. |
cena:
308,19 |
 |
Violencia Intrafamiliar en Venezuela. Caso: Niños, Niñas y Adolescente : Reglamento Interno para el Consejo Comunal Casco Central, El Moralito, Municipio Colón
ISBN: 9786202247276 / Hiszpański / Miękka / 2017 / 160 str. Termin realizacji zamówienia: ok. 10-14 dni roboczych. |
cena:
290,29 |
 |
SARS-CoV-2 e COVID-19 in Venezuela
ISBN: 9786205892312 / Włoski Termin realizacji zamówienia: ok. 10-14 dni roboczych. |
cena:
357,39 |
 |
SARS-CoV-2 et COVID-19 au Venezuela
ISBN: 9786205892305 / Francuski Termin realizacji zamówienia: ok. 10-14 dni roboczych. |
cena:
357,39 |
 |
SARS-CoV-2 und COVID-19 in Venezuela
ISBN: 9786205892299 / Niemiecki Termin realizacji zamówienia: ok. 10-14 dni roboczych. |
cena:
357,39 |
 |
SARS-CoV-2 e COVID-19 na Venezuela
ISBN: 9786205892350 / Portugalski Termin realizacji zamówienia: ok. 10-14 dni roboczych. |
cena:
357,39 |
 |
SARS-CoV-2 and COVID-19 in Venezuela
ISBN: 9786205892282 / Angielski Termin realizacji zamówienia: ok. 10-14 dni roboczych. |
cena:
357,39 |
 |
Boro y osteoporosis, tratamiento y biomarcadores de metabolismo óseo : Biomarcadores de metabolismo óseo, boro y osteoporosis, técnicas para la determinación de boro, tratamiento
ISBN: 9783841757906 / Hiszpański / Miękka / 2016 / 188 str. Termin realizacji zamówienia: ok. 10-14 dni roboczych. |
cena:
290,29 |
 |
El SARS-CoV-2 y la COVID-19 en Venezuela
ISBN: 9783841755834 / Hiszpański / Miękka / 188 str. Termin realizacji zamówienia: ok. 10-14 dni roboczych. |
cena:
357,39 |
 |
Agraroekologie in Venezuela
ISBN: 9786206112051 / Niemiecki Termin realizacji zamówienia: ok. 10-14 dni roboczych. |
cena:
308,19 |
 |
Agroecology in Venezuela
ISBN: 9786206112082 / Angielski Termin realizacji zamówienia: ok. 10-14 dni roboczych. |
cena:
308,19 |
 |
Agroecologia in Venezuela
ISBN: 9786206112105 / Włoski Termin realizacji zamówienia: ok. 10-14 dni roboczych. |
cena:
308,19 |











